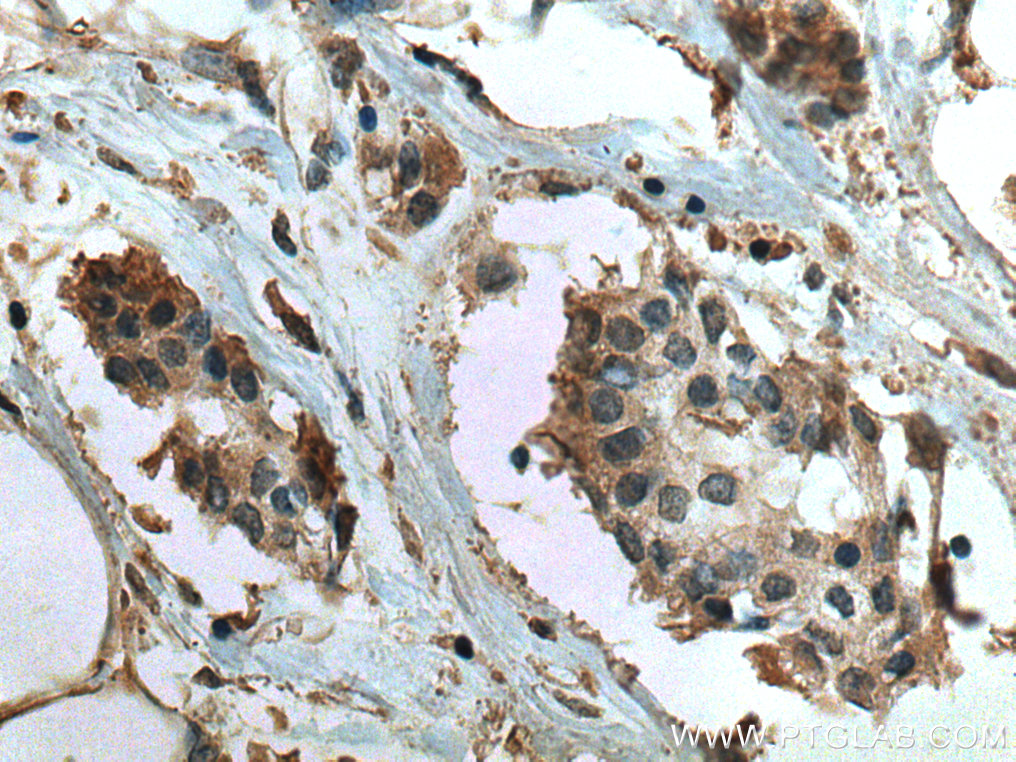

验证数据展示
经过测试的应用
| Positive WB detected in | Jurkat cells, HeLa cells, THP-1 cells, U-937 cells, NCCIT cells, human brain tissue, pig brain tissue, HEK-293 cells, Ramos cells, Daudi cells, Raji cells, pig spleen tissue |
| Positive IHC detected in | human urothelial carcinoma tissue, human lung cancer tissue, human breast cancer tissue Note: suggested antigen retrieval with TE buffer pH 9.0; (*) Alternatively, antigen retrieval may be performed with citrate buffer pH 6.0 |
| Positive IF/ICC detected in | HeLa cells |
推荐稀释比
| 应用 | 推荐稀释比 |
|---|---|
| Western Blot (WB) | WB : 1:1000-1:6000 |
| Immunohistochemistry (IHC) | IHC : 1:200-1:800 |
| Immunofluorescence (IF)/ICC | IF/ICC : 1:50-1:500 |
| It is recommended that this reagent should be titrated in each testing system to obtain optimal results. | |
| Sample-dependent, Check data in validation data gallery. | |
产品信息
66755-1-Ig targets TRAF4 in WB, IHC, IF/ICC, ELISA applications and shows reactivity with human, pig samples.
| 经测试应用 | WB, IHC, IF/ICC, ELISA Application Description |
| 文献引用应用 | WB, IHC, IF |
| 经测试反应性 | human, pig |
| 文献引用反应性 | human, mouse |
| 免疫原 |
CatNo: Ag27221 Product name: Recombinant human TRAF4 protein Source: e coli.-derived, PET28a Tag: 6*His Domain: 35-307 aa of BC001769 Sequence: GHRFCDTCLQEFLSEGVFKCPEDQLPLDYAKIYPDPELEVQVLGLPIRCIHSEEGCRWSGPLRHLQGHLNTCSFNVIPCPNRCPMKLSRRDLPAHLQHDCPKRRLKCEFCGCDFSGEAYESHEGMCPQESVYCENKCGARMMRRLLAQHATSECPKRTQPCTYCTKEFVFDTIQSHQYQCPRLPVACPNQCGVGTVAREDLPGHLKDSCNTALVLCPFKDSGCKHRCPKLAMARHVEESVKPHLAMMCALVSRQRQELQELRRELEELSVGSD 种属同源性预测 |
| 宿主/亚型 | Mouse / IgG1 |
| 抗体类别 | Monoclonal |
| 产品类型 | Antibody |
| 全称 | TNF receptor-associated factor 4 |
| 别名 | 2C9A11, CART1, Cysteine-rich domain associated with RING and Traf domains protein 1, EC:2.3.2.27, MLN 62 |
| 计算分子量 | 54 kDa |
| 观测分子量 | 50-54 kDa |
| GenBank蛋白编号 | BC001769 |
| 基因名称 | TRAF4 |
| Gene ID (NCBI) | 9618 |
| RRID | AB_2882101 |
| 偶联类型 | Unconjugated |
| 形式 | Liquid |
| 纯化方式 | Protein G purification |
| UNIPROT ID | Q9BUZ4 |
| 储存缓冲液 | PBS with 0.02% sodium azide and 50% glycerol, pH 7.3. |
| 储存条件 | Store at -20°C. Stable for one year after shipment. Aliquoting is unnecessary for -20oC storage. |
背景介绍
The tumor necrosis factor receptor-associated factor (TRAF) family, consisting of seven members (TRAF1-7), is a group of signaling adaptors which participate in various signaling pathways through binding of the tumor necrosis factor receptor superfamily. As one of the important member of TRAF family proteins, TRAF4 was initially isolated from breast carcinomas and identified as the first member of the TRAF family to be up-regulated in human carcinomas. TRAF4 is required during embryogenesis in key biological processes including the formation of the trachea, the development of the axial skeleton, and the closure of the neural tube. TRAF4 deficiency leads to severe developmental alterations.
实验方案
| Product Specific Protocols | |
|---|---|
| IF protocol for TRAF4 antibody 66755-1-Ig | Download protocol |
| IHC protocol for TRAF4 antibody 66755-1-Ig | Download protocol |
| WB protocol for TRAF4 antibody 66755-1-Ig | Download protocol |
| Standard Protocols | |
|---|---|
| Click here to view our Standard Protocols |
发表文章
| Species | Application | Title |
|---|---|---|
Int J Mol Sci TRAF4 Promotes the Proliferation of Glioblastoma by Stabilizing SETDB1 to Activate the AKT Pathway
| ||
Anticancer Drugs High expression of TRAF4 predicts poor prognosis in tamoxifen-treated breast cancer and promotes tamoxifen resistance.
| ||
Adv Sci (Weinh) TRAF4-Mediated LAMTOR1 Ubiquitination Promotes mTORC1 Activation and Inhibits the Inflammation-Induced Colorectal Cancer Progression
| ||